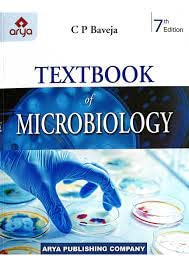
Textbook of Microbiology

Textbook of Microbiology
Textbook of Microbiology is backordered and will ship as soon as it is back in stock.
Couldn't load pickup availability
Genuine Products Guarantee
Genuine Products Guarantee
We guarantee 100% genuine products, and if proven otherwise, we will compensate you with 10 times the product's cost.
Delivery and Shipping
Delivery and Shipping
Products are generally ready for dispatch within 1 day and typically reach you in 3 to 5 days.
Book Details
-
Publisher: Rawat Publications
-
Language: English
-
Edition: —
-
Pages: 690
-
Cover: Paperback
-
ISBN: 9789394102477
-
Weight: 1.32 kg
About the Book
Published by Rawat Publications, this 690-page English paperback offers a comprehensive and well-structured academic resource suitable for students, educators, and professionals. Designed for depth and clarity, the book provides detailed explanations, easy readability, and organized chapter flow to support effective learning. Its extensive coverage makes it a reliable reference for coursework, exam preparation, and long-term academic use. With a balanced approach to concept-building and practical understanding, this volume serves as a dependable study companion across diverse learning needs.